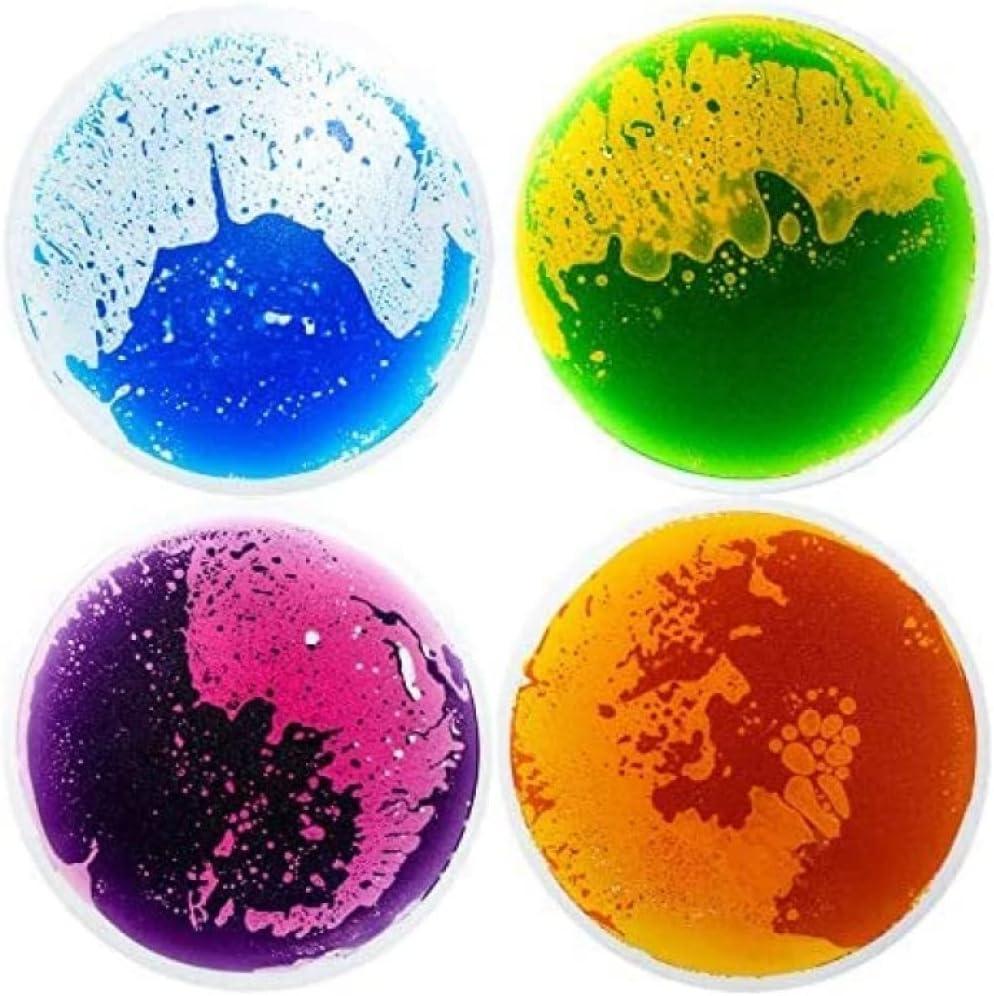

Description
Vibrant Liquid Motion – Each tile encases a colorful, non-toxic liquid that moves and swirls responsively under pressure, creating an ever-changing visual display that stimulates sensory interaction and exploration
Easy & Flexible Placement – Our liquid sensory tiles require no installation, allowing for effortless placement in any corner of a house, school or as decorative elements
Anti-Slip Backing – Equipped with a specially designed anti-slip backing, these tiles ensure a safe and stable surface, reducing the risk of slips and falls, making them suitable for high-traffic and active play areas
Recommended Use – Children's play house / Kids room floor/ Dance floor / Play mat / Fashion stores / Chair mat / Classroom
What You Got – Set of 4 triangle liquid sensory floor tile, each size of 15″x15″, providing ample coverage and easy configuration options in various settings. Our 24/7 professional customer service, feel free to contact us if you have any problems

Reviews
There are no reviews yet.